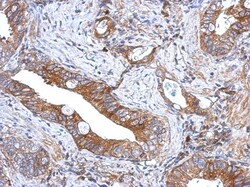
GCNT3 Antibody, Novus Biologicals 0.1 mL | Buy Online | Novus Biologicals | Fisher Scientific

missing translation for 'onlineSavingsMsg'
Läs mer
Läs mer
Beskrivning
GCNT3 Polyclonal specifically detects GCNT3 in Human samples. It is validated for Western Blot, Immunohistochemistry, Immunohistochemistry-Paraffin.

Specifikationer
Specifikationer
| Antigen | GCNT3 |
| Användningsområden | Western Blot, Immunohistochemistry, Immunohistochemistry (Paraffin) |
| Klassificering | Polyclonal |
| Koncentration | 1mg/mL |
| Konjugera | Unconjugated |
| Utspädning | Western Blot 1:500-1:3000, Immunohistochemistry 1:100-1:1000, Immunohistochemistry-Paraffin 1:100-1:1000 |
| Formulering | 0.1M Tris (pH 7.0), 0.1M Glycine and 20% Glycerol with 0.01% Thimerosal |
| Genaccessionsnr. | O95395 |
| Gene Alias | beta-1,3-galactosyl-O-glycosyl-glycoproteinbeta-1,6-N-acetylglucosaminyltransferase 3, beta1,6GlcNAc-transferase, beta1,6-N-acetylglucosaminyltransferase-M, C2/4GnTGNTM, C24GNT, C2GnT2, C2GnT-M, C2GNTM, C2GnT-mucin type, Core 2/core 4 beta-1,6-N-acetylglucosaminyltransferase, EC 2.4.1.102, EC 2.4.1.150, glucosaminyl (N-acetyl) transferase 3, mucin type, hC2GnT-M, mucus-type core 2 beta-1,6-N-acetylglucosaminyltransferase |
| Gensymboler | GCNT3 |
| Visa mer |
For Research Use Only
Produkttitel
Genom att klicka på Skicka bekräftar du att du kan bli kontaktad av Fisher Scientific angående feedbacken du har lämnat i detta formulär. Vi kommer inte att dela din information för andra ändamål. All kontaktinformation som tillhandahålls ska också underhållas i enlighet med vår Sekretesspolicy.
Hittar du en möjlighet till förbättring?